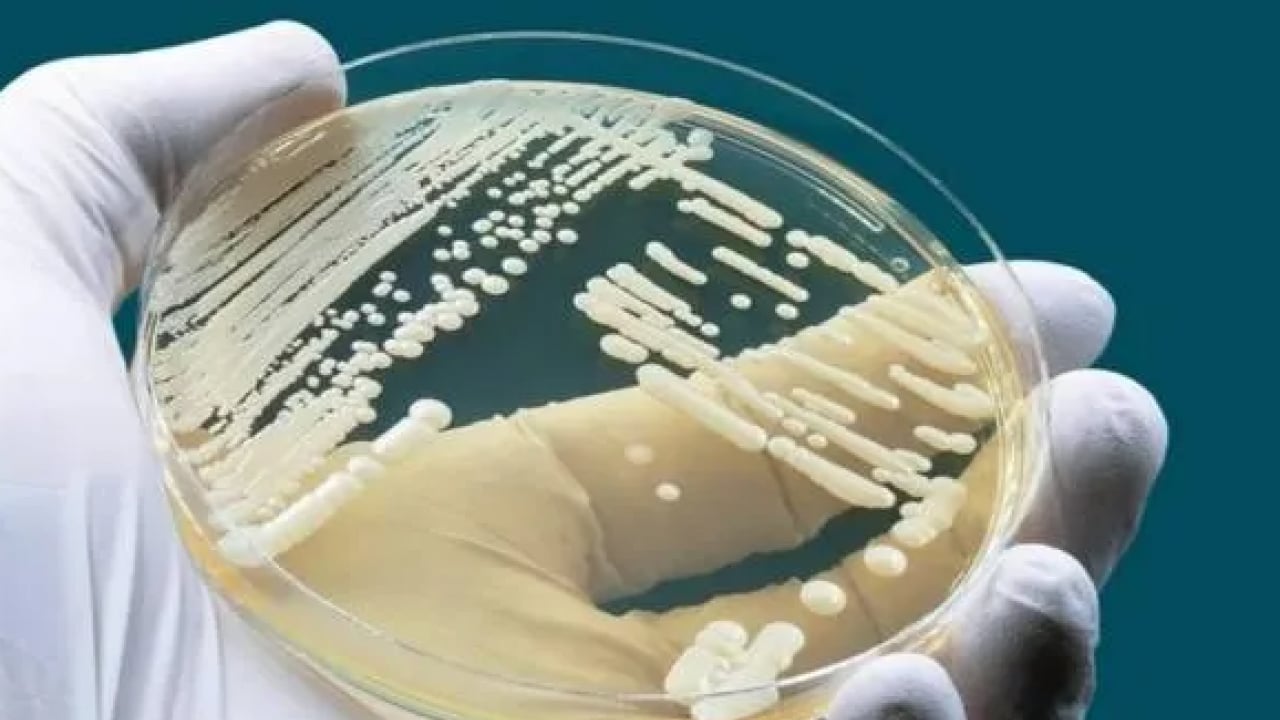
Foto - 2 yaşındaki Ali ölümden döndü: Bocavirüs'ün belirtileri neler?

2 yaşındaki Ali ölümden döndü: Bocavirüs'ün belirtileri neler?
Erzincan'da grip benzeri üst solunum yolu enfeksiyona neden olan bocavirüse yakalanan 3 yaşındaki Ali Enfal Baki'nin iki kez kalbi durdu.
Erzincan'da grip benzeri üst solunum yolu enfeksiyona neden olan bocavirüse yakalanan 3 yaşındaki Ali Enfal Baki'nin iki kez kalbi durdu.
Erzincan'da yaşayan Gülay ve Tekin Baki çiftinin tek çocuğu olan Ali Enfal, öksürük ve yüksek ateş şikayetiyle hastaneye götürüldü. İlk kontrollerin ardından ilaç verilerek eve gönderilen küçük çocuğun durumu kısa sürede ağırlaştı.
Nadir görülen ve grip benzeri üst solunum yolu enfeksiyonuna yol açan bocavirüse yakalanan Baki, nefes darlığı ve hırıltı şikayetlerinin artması üzerine yeniden hastaneye kaldırıldı. Küçük çocuk burada yapılan diyaliz ve destek tedavileriyle organ nakline gerek kalmadan sağlığına kavuştu.
İŞTE BELİRTİLERİ Bocavirüs (Human Bocavirus / HBoV), özellikle bebekler ve küçük çocuklarda görülen, çoğunlukla solunum yolu enfeksiyonlarına neden olabilen bir virüstür.
Bocavirüs enfeksiyonu genellikle soğuk algınlığına benzer şekilde seyreder; en sık ateş, burun akıntısı/tıkanıklığı, boğaz ağrısı, halsizlik ve özellikle öksürük görülür.
Bazı kişilerde hırıltılı solunum, nefes darlığı, hızlı nefes alıp verme gibi alt solunum yolu belirtileri gelişebilir ve bronşiolit veya zatürre tablosuna ilerleyebilir.
Daha az sıklıkla ise kusma, ishal gibi mide-bağırsak şikâyetleri de eşlik edebilir./ kaynak: ensonhaber
WhatsApp İhbar Hattı
+90 (553) 313 94 23